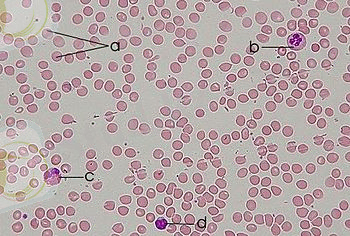
350px-Blood_smear.jpg

Жануарлардан қан алу әдістері және қанның физикалық қасиеттерін анықтау


Қазақстан Республикасының Білім және Ғылым министрлігі
Семей қаласының Шәкәрім атындағы Мемлекеттік Университеті.
БӨЖ
Тақырыбы : Қан алу және оның физикалық қасиеттерін анықтау.
Орындаған: Сабырғалиева А. Қ.
Тексерген: Муратбаев Д. М.
Семей 2015.
Жоспар:
- Кіріспе.
- Негізгі бөлім:
- Әр түрлі жануарлардан қан алу тәсілдері;
- Жылқы, ірі қара және ұсақ малдан қан алу әдістері;
- Шошқадан қан алу;
- Иттен қан алу;
- Қояннан қан алу;
- Теңіз доңызынан қан алу;
- Егеуқүйрық пен тышқаннан қан алу;
- Қанның физикалық қасиеттерін анықтау.
- Қорытынды бөлім.
- Пайдаланылған әдебиеттер тізімі.
Кіріспе
Қан (гр. haemo ; лат. sanguis - қан) - ағзадағы ішкі сұйық ортаның бірі. Ол қантамырларының тұйық жүйесін бойлай ағып, тасымалдау қызметін атқарады. Қан барлық мүшелердің жасушаларына қоректік заттар мен оттегін жеткізеді және тіршілік әрекетінің өнімдерін зәр шығару мүшелеріне тасымалдайды. Организмдегі биологиялық әрекетшіл заттардың гуморальдық реттелу қызметі қанның қатысуымен іске асады. Қан ағзаның инфекциядан қорғаныш реякциясын қамтамасыз етеді.
Қанның қызметтері:
- асқорыту - қан, ұлпалар мен мүшелерге қоректік заттарды, суды, минералды тұздарды және витаминдерді тасымалдайды;
- бөліп шығару - қан бөліп шығару мүшелері арқылы ыдырау өнімдерін шығарады;
- тыныс алу - өкпе мен ұлпалардың арасында газ алмасу процесін қамтамасыз етеді;
- регуляторлық - әр түрлі мүшелердің гуморальдық реттелуін анықтайды, ағзада гормондар мен басқа заттарды жеткізеді, олар мүшелердің қызметіне әсер етеді (күшейтеді немесе бәсеңдетеді)
- қорғаныш - қанның құрамында фагоцит қабілеті бар жасушалар болады және арнайы ақуыздар - антиденелер болады, олар улы ағзалардың көбеюіне кедергі жасайды да оларды бөліп шығарады.
- терморегуляторлық - қан ағзаның тұрақты дене қызуын сақтайды.
Қанның құрамы:
a - эритроцит; b - нейтрофиль;
c -эозофиль; d - лейкоцит.
Әр түрлі жануарлардан қан алу тәсілдері
Малдан қап алу үшін қан алынатын жердің жүнін қырқып, немесе қырып, теріні спиртпен тазалайды да, тамырды стерильденген арнаулы инемен теседі. Қанды аз мөлшерде алған жағдайда малды онша күш жұмса-май үстаған дұрыс. Кейбір жағдайларда ұсақ мал мен қүстан канды тікелей жүрек қарыншасынан алады.

Жылқы, ірі қара және ұсақ малдан қан алу әдістері. Аздаған қанды құлақтың вена тамырларынан алады. Тамыр орналасқан жерді тазартқан соң, оны арнаулы инемен теседі де, шыққан қан тамшысын шыны түтікшемен сорып алады. Тамырдан шыққан бірінші тамшыны құрғақ таза мақтамен сүртіп тастаған жөн, сонда қан тамшысы жайылмайды, оны сорып алу оңайлайды. Көп қанды ойыс венадан алады. Ол үшін малды қимылдамайтындай етіп байлайды да, теріні тазартып, қан алатын тамырды бас бармақпен баса ұстайды.


Қан тамырға жиналып, тамыр анық көрінеді. Арнайы стерильденген инемен тері мен тамырды көлбей теседі (ине шамамен 45° бұрышпен қадалу керек) . Қан аға бастағанда инеге таза ыдыстытосып, керекті мөлшерде қан алады. Соңғы кезде қан алу үшін арнаулы аспап - автоматтар пайдаланылады. Созылмалы тәжірибелерде терең орналасқан қан тамырларынан (қақпалық, бауыр, артқы қолқа, мес қарын тамырлары және басқа веналардан) ұзақ уақыт қан алу үшін катетерлеу әдісі қолданылады.
Шошқадан қан алу. Шошқаның үлкен құлақ венасынскальпелмен тілу арқылы аздаған мөлшерде қан алады. Ол үшін тамырдың орталық бөлігін құлақ түбінен саусақпен қысып тұрады.


Қанды көп мөлшерде алу үшін қайшы немесе скальпелменқұйрықтың ұшынан 1 -1, 5 см шамасында кесіп тастайды. Қан алып болған соң, жараны дезинфекциялап, құйрықтың ұшын 1-2 тәулік бойына бинтпен таңып тастайды.
Торайлардан 5-30 мл мөлшеріпде қан алу үшін оларды шалқасынан жатқыза байлап қойып, көмегімен орбитальды вена синусынтеседі.
Иттен қан алу. Иттен (мысыктан) қанды аз мөлшерде құлағының ұшынан алады. Көп мөлшердегі қанды асық жіліктің сырт жағын ала, тірсектен төмен орналасқаң сирақ венасынан алады. Итті бір бүйіріне жатқы-зып, немесе станокқа бекітіп, аяқтарын қолмен қыса ұстап, тірсектің төменгі жағынан резеңке бұрау салады да, инеменалдыментеріні, одан соң венаның қабырғасын тесіп, қанды шприцпен сорып алады.

Қояннан қан алу. Қояннан қанды аз мөлшерде құлақтың ұшын тіліп, немесеқұлақ венасынаналады. Бұл кездеқоянды сүлгімен орайды, немесе басы шығып тұратын арнаулы тесігі бар жәшікке отырғызады. Құлақты алдын ала жылысуға салған, немесексилолмен(спиртпен) сүрткен жөн.
Қанды көп мелшерде кеуде венасынаналады. Олүшін операциялық алаңды (шынтақ төмпешігінен үшінші қабырғаға дейін) дайындап болған соң, венаны саусақпен басып тұрып, инені қан ағысына қарсы бағытта көлбеу енгізеді.
Кейде қанды тікелей жүректің өзінен алады. Қояннан 15-20 мл-ге дейін қан алуға болады.

Теңіз доңызынан қан алу. Теңіз доңызынан қанды аз мөлшерде құлағынын, ұшын тіліп немесе табанын франк инесімен тесу арқылы алады. Қанды көп мөлшерде ойыс венадан (теріні кесіп, қан тамырын оқшаулағаннан кейін) немесе тікелей жүректен арнаулы инемен алады. Инені төс сүйегінің сол жағын ала, жүрек қағысы анық сезіліп түрған жерден қадайды. Инені 1, 5- 2 см тереңдікке енгізу керек. Бір алғанда 5-10 мл қан алуға болады.
Егеуқүйрық пен тышқаннан қан алу. Егеуқүйрық пен тышқаннан қанды құлағының ұшын тіліп, немесеқұйрығының ұшын кесіп алады. Үлкен егеуқұйрықтан қанды кұйрық венасынан да алуға болады. Ол үшін кұйрықты алдын ала жылы суға салады да, дәкемен құрғатып сүртеді. Содан соң құйрық түбін саусақпен кыса ұстап, венаға жіңішке ине кіргізеді де, қанды шприцпен сорады.
Құстанқан алу. Тауықтан қанды аз мөлшерде оның айдарын тіліп, ал қаз бен үйректен жұмсақ табанын тесіп алады. Құстан қанды көп мөлшерде, канаттарының астыңғы жағында орналасқан қанат асты венадан алады. Ол үшін қауырсындарды жұлып тастап, топшы тұсынан венаны саусақпен қыса ұстап, инені тамырға көлбей енгізеді.
Қүстың қаны өте тез ұйитын болғандықтан, қан алатын жерді алдын ала қан ұйытпайтын сұйықтықпен (антикоагулянтпен) сүртеді. Шыққан қанды пипеткамен Ішінде антикоагулянты бар пробиркаға кұяды.
Тауықтан, қаздан, түйетауықтан бір ретте 10-15 мл, көгершіннен -1 -1, 5 мл қан алуға болады.

Бақаданқан алу. Бақаның бірнеше тамшы қанын саусақтарының ұшын қайшымен кесіп тастап, алуға болады. Қанды кейде қурсағының ортасында орналасқан тері венасын тесіп алады (алдын ала теріні кеседі) . Көп жағдайда қанды бақаның кеудесін ашып, тікелей жүрегінен алады.
Қанның физикалық қасиеттерін анықтау.
Қанның салыстырмалы тығыздығы мен ЭТЖ анықтаудың клиникалық маңызы өте зор. Қанның салыстырмалы тығыздығын анықтау. Қанның салыстырмалы тығыздығын әрі плазмамен сарысудың салыстырмалы тығыздығын Филлипс әдісімен анықтайды. Мыстың қанық сульфатын дайындау үшін 900гр бес сулы сульфатын ұнтаққа айналдырып үгіп, 1250 мл дистильденген су құйып, әйнек таяқшасымен мұқият 5 мин араластырады. Ерітіндінің температурасын 0, 5 С 0 дейін анықтап сүзіп алады. Алынған ерітіндіден 1, 100 салыстырмалы тығыздығы бар негізгі ерітіндіні жасайды Бұл үшін негізгі ерітіндінің 15гр С 0 529 мл алып, дистильденген сумен 1л жеткізеді. Ерітіндінің мөлшері оның температурасына байланысты. Мысалы, 15, 5 С гр 525 мл; 16 0 521; 19 0 496; 15, 5 0 492гр; 20 0 488; 20, 5 0 484; 21 0 480; 21, 5 0 477; 22 0 473.
Негізгі қалыпты ерітіндіден тығыздығы 1, 030 дан 0, 075 дейін мыс сульфатының жұмысшы ерітіндісін жасайды. Өлшегіш колбаға дайындалатын ерітіндінің соңғы 2 сандарының тығыздығына сәйкес келетін қалыпты ерітінді құйып алады да, дистильденген сумен 100 мл жеткізеді. Мысалы, тығыздығы 0, 050 ерітіндіні дайындау үшін 49 мл негізгі қалыпты ерітіндіден алып, 100 мл дейін су қосады. Ерітіндіні қақпағы жабылған қараңғы ыдыстарда сақтайды. Анализ үшін гепаринмен, натрий оксалатымен, Б трилонымен қалыпқа түскен қанды пайдалануға болады, центрифугаланған қанды зерттеу үшін жарамсыз.
... жалғасы- Іс жүргізу
- Автоматтандыру, Техника
- Алғашқы әскери дайындық
- Астрономия
- Ауыл шаруашылығы
- Банк ісі
- Бизнесті бағалау
- Биология
- Бухгалтерлік іс
- Валеология
- Ветеринария
- География
- Геология, Геофизика, Геодезия
- Дін
- Ет, сүт, шарап өнімдері
- Жалпы тарих
- Жер кадастрі, Жылжымайтын мүлік
- Журналистика
- Информатика
- Кеден ісі
- Маркетинг
- Математика, Геометрия
- Медицина
- Мемлекеттік басқару
- Менеджмент
- Мұнай, Газ
- Мұрағат ісі
- Мәдениеттану
- ОБЖ (Основы безопасности жизнедеятельности)
- Педагогика
- Полиграфия
- Психология
- Салық
- Саясаттану
- Сақтандыру
- Сертификаттау, стандарттау
- Социология, Демография
- Спорт
- Статистика
- Тілтану, Филология
- Тарихи тұлғалар
- Тау-кен ісі
- Транспорт
- Туризм
- Физика
- Философия
- Халықаралық қатынастар
- Химия
- Экология, Қоршаған ортаны қорғау
- Экономика
- Экономикалық география
- Электротехника
- Қазақстан тарихы
- Қаржы
- Құрылыс
- Құқық, Криминалистика
- Әдебиет
- Өнер, музыка
- Өнеркәсіп, Өндіріс
Қазақ тілінде жазылған рефераттар, курстық жұмыстар, дипломдық жұмыстар бойынша біздің қор #1 болып табылады.



Ақпарат
Қосымша
Email: info@stud.kz